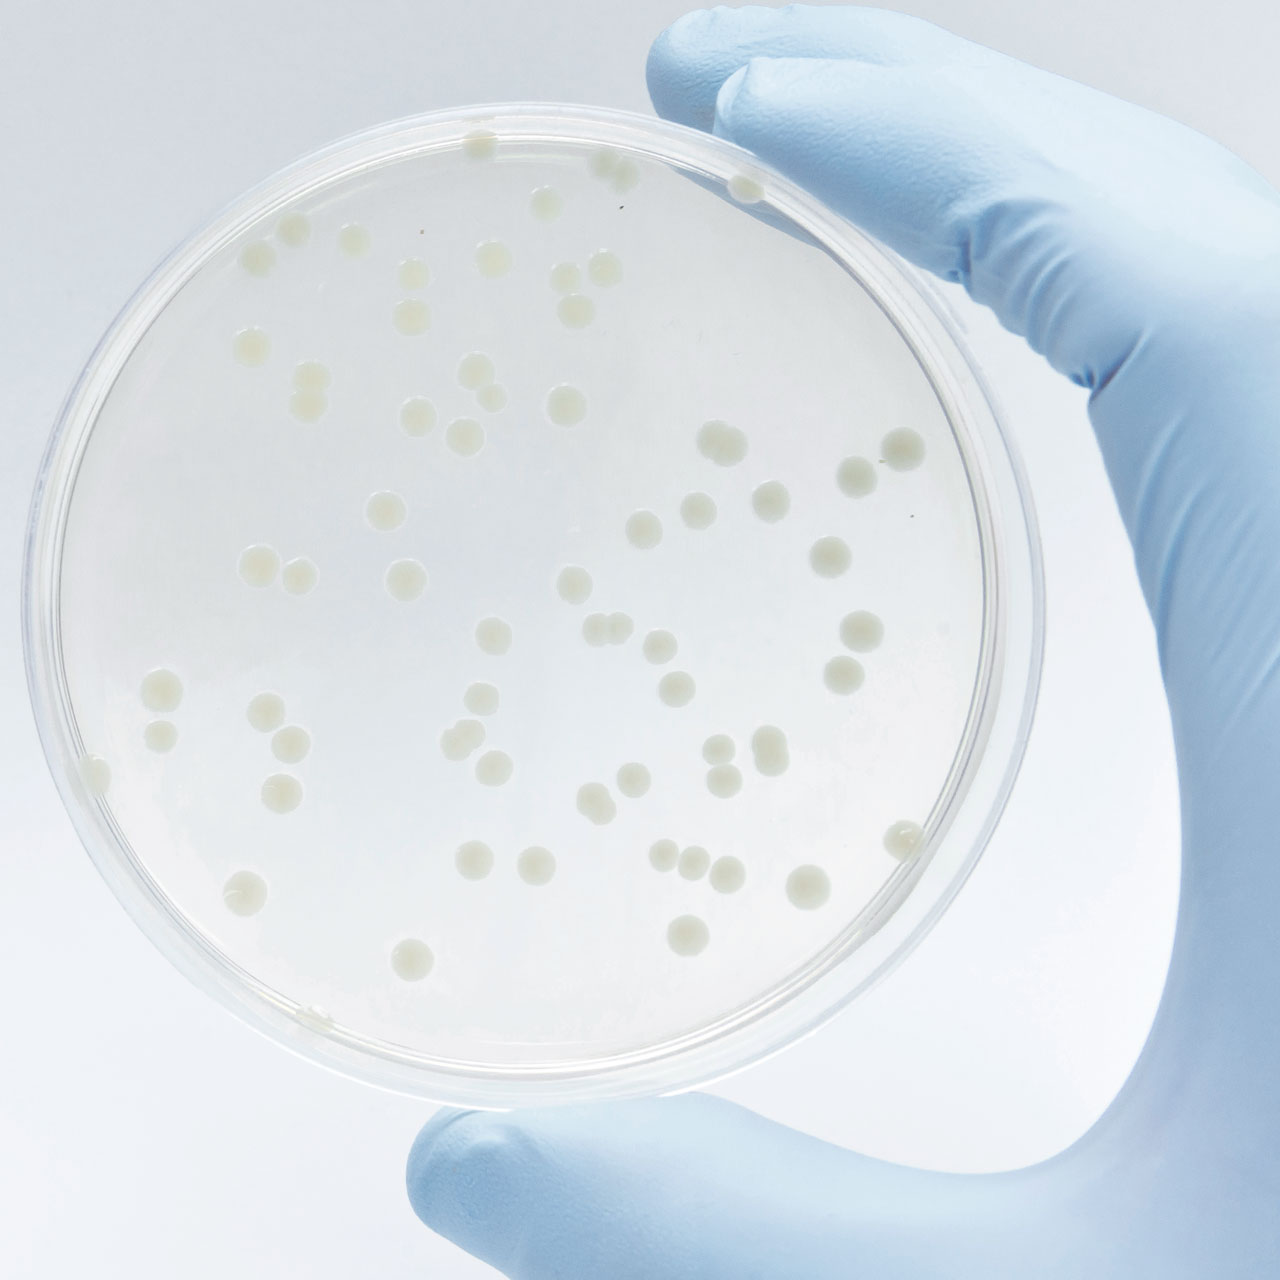
Legionellen

Legionellen im Wasser
Legionellen sind für Menschen gefährliche Stäbchenbakterien, welche für die sogenannte Legionärskrankheit oder Legionellose verantwortlich sind. Diese geht typischerweise mit einer schweren Lungenentzündung, Fieber und weiteren Symptomen einher. Die Fallzahlen in der Schweiz sind seit vielen Jahren am Steigen, was dem unerwünschten Keim seine Bekanntheit verschafft hat. Überall dort, wo Duschen, Whirlpools oder Klimaanlagen vorhanden sind, können Legionellen auftreten. Die Ansteckung erfolgt nicht über das Trinken, sondern über Aerosole - kleinste Flüssigkeits-Tröpfchen in der Luft, die in die Lunge gelangen.
Vorkommen und Vermehrung
Legionellen kommen grundsätzlich überall in der Natur vor und sind dort meist ungefährlich. Den Unterschied macht die Anzahl der Keime im Wasser aus. Bei Temperaturen von 25 bis 45 °C vermehren sich Legionellen bevorzugt, bis sie schliesslich gefährliche Konzentrationen erreichen. Nährstoffe, Stagnation des Wassers, Kalkbeläge und Korrosion begünstigen bei diesen Wassertemperaturen das Wachstum von Biofilmen, in denen sich Legionellen in Gebäudeinstallationen gut geschützt vermehren können. Legionellen kommen hauptsächlich in älteren Wasserleitungen, Klimaanlagen oder Schwimmbädern vor. Ein erhöhtes Risiko bergen auch verzweigte Wassersysteme von Gebäuden wie Krankenhäusern, Altersheimen, Pflegeheimen, Hotels sowie Bad- und Wellnesseinrichtungen in sich.

Legionellen vorbeugen
Mit drei einfachen Grundregeln kann jeder dazu beitragen, wasserführende Systeme keimfrei zu halten.
Analyse-Möglichkeiten
Mit regelmässigen Untersuchungen stellen wir sicher, dass unser Trinkwasser unter Kontrolle bleibt. Wir unterstützen Sie gerne mit unserer Erfahrung und unseren Lösungen zu verschiedenen Problemstellungen rund um Legionellen. Dabei kann es sowohl um Präventionsmassnahmen, Nachkontrollen als auch die Identifikation kritischer Anlagenteile handeln.
Legionellen im Wasser beseitigen
Wasseranalysen
Von der einmaligen Untersuchung bis hin zum systemweiten Monitoring: Wir helfen gerne bei der Ermittlung und Interpretation Ihrer Wasserqualität.Wir beraten Sie gerne unverbindlich.
per Telefon: 079 465 11 27Downloads
| Flyer Legionellen | PDF, 3 Mb | Download |